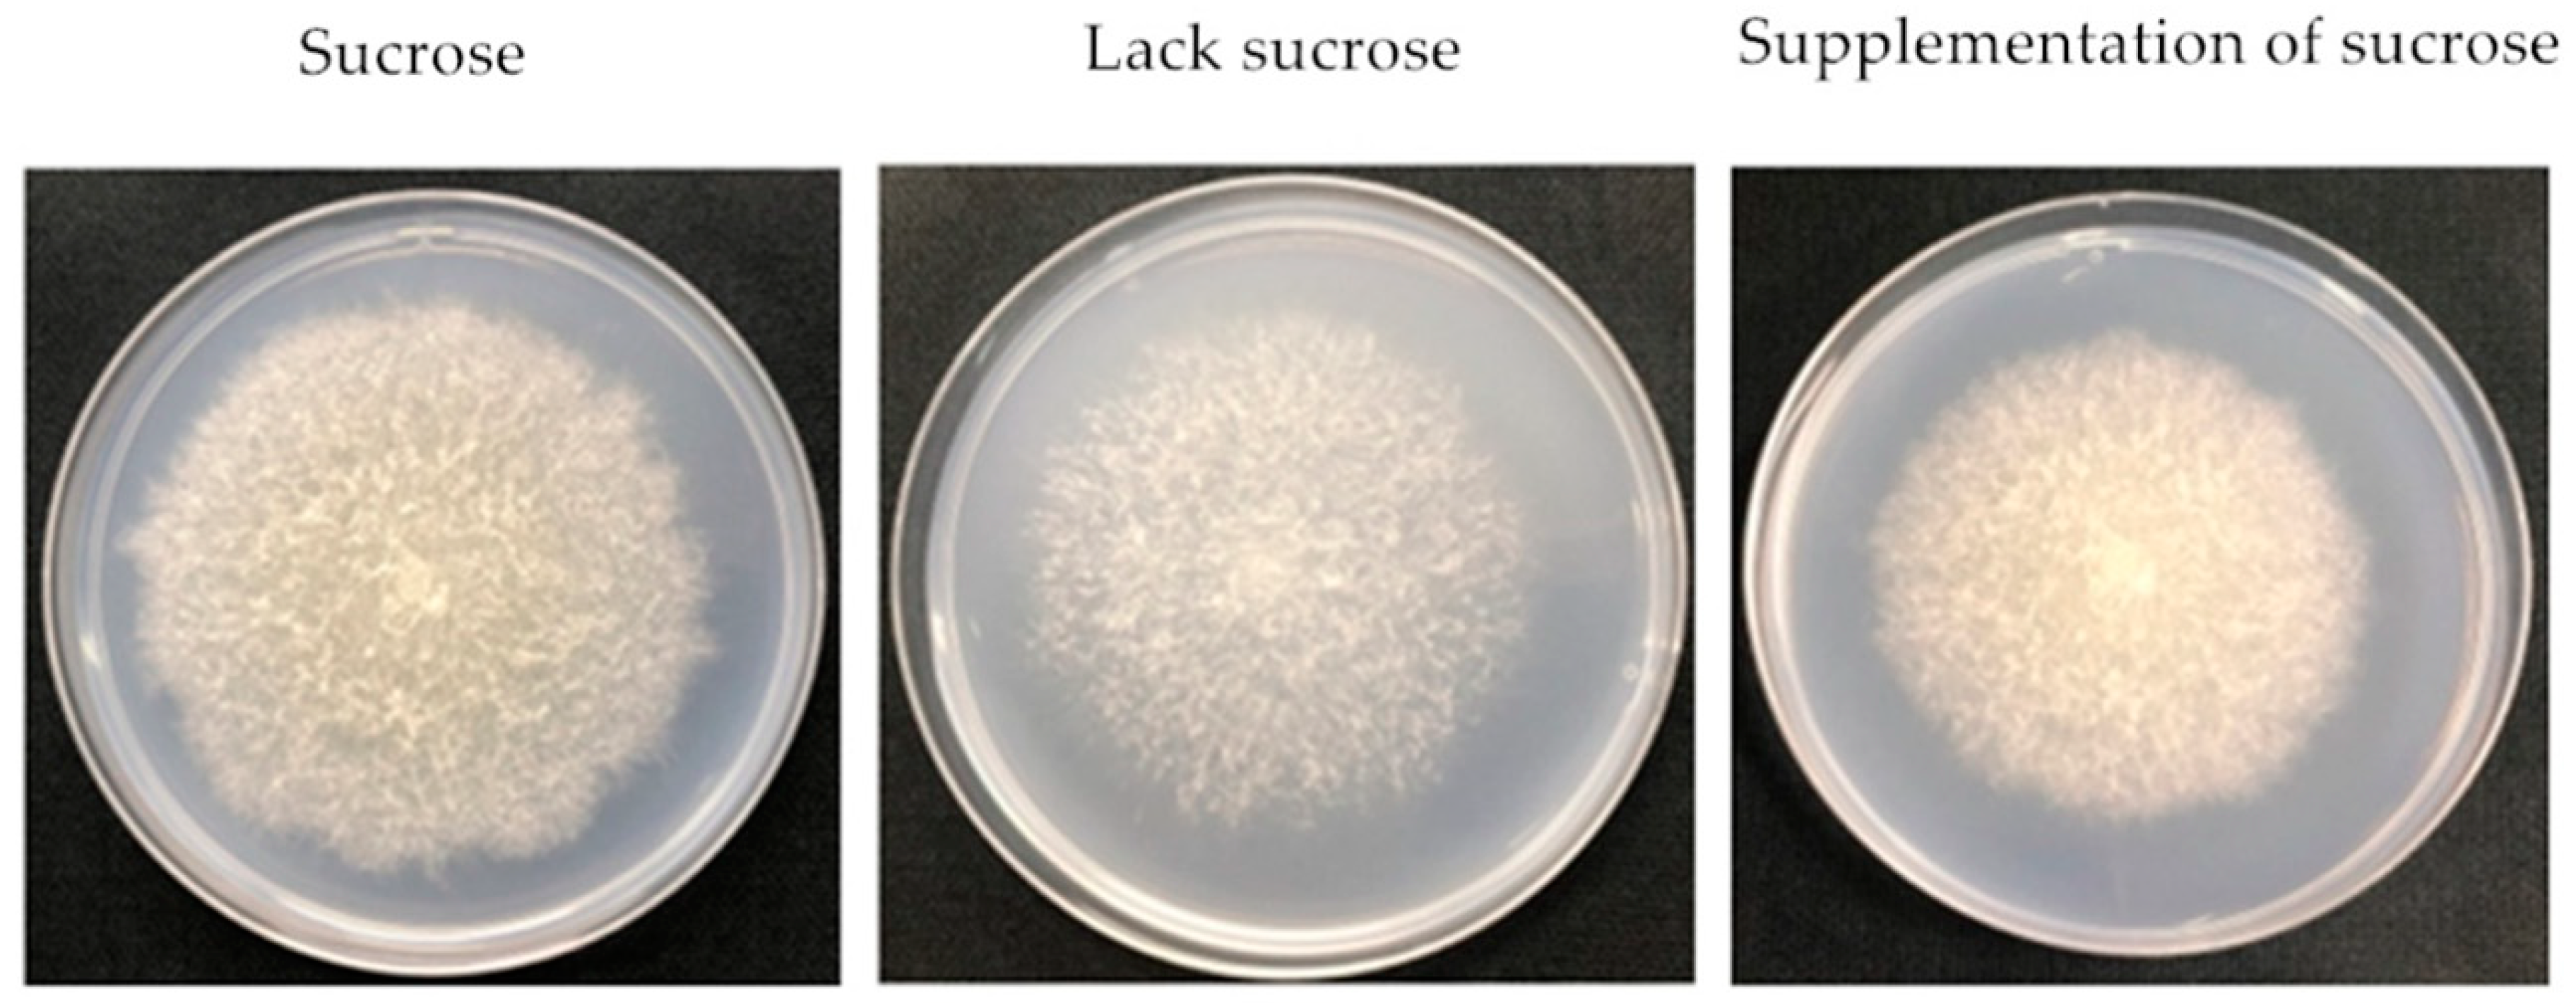

Effects of Different Carbon Sources on Fumonisin Production and FUM Gene Expression by Fusarium proliferatum
Abstract
1. Introduction
2. Results
2.1. Effect of Different Sucrose Conditions on the Growth, Sporulation and FB1 Content of F. Proliferatum
2.2. Effect of Different Carbon Sources on the Growth, Sporulation and FB Content of F. Proliferatum
2.3. Effect of Different Carbon Sources on the Expressions of FB-Related Genes
3. Discussion
4. Conclusions
5. Materials and Methods
5.1. Fungal Strain and Growth Condition
5.2. Polysaccharide Extraction
5.3. Fumonisin Analysis
5.4. RNA Isolation and cDNA Synthesis
5.5. Expression Analysis by Real-Time Quantitative PCR
5.6. Statistical Analysis
Supplementary Materials
Author Contributions
Funding
Conflicts of Interest
References
- Berthiller, F.; Crews, C.; Dall’Asta, C.; Saeger, S.D.; Haesaert, G.; Karlovsky, P.; Oswald, I.P.; Seefelder, W.; Speijers, G.; Stroka, J. Masked mycotoxins: A review. Mol. Nutr. Food Res. 2013, 57, 165–186. [Google Scholar] [CrossRef] [PubMed]
- Bennett, J.W.; Klich, M. Mycotoxins. Clin. Microbiol. Rev. 2003, 16, 497–516. [Google Scholar] [CrossRef] [PubMed]
- Gorna, K.; Pawlowicz, I.; Waskiewicz, A.; Stepien, L. Fusarium proliferatum strains change fumonisin biosynthesis and accumulation when exposed to host plant extracts. Fungal Biol. 2016, 120, 884–893. [Google Scholar] [CrossRef] [PubMed]
- Rheeder, J.P.; Marasas, W.F.O.; Vismer, H.F. Production of fumonisin analogs by Fusarium species. Appl. Environ. Microbiol. 2002, 68, 2101–2105. [Google Scholar] [CrossRef] [PubMed]
- Li, R.; Tao, B.; Pang, M.; Liu, Y.; Dong, J. Natural occurrence of fumonisins B1 and B2 in maize from three main maize-producing provinces in China. Food Control 2015, 50, 838–842. [Google Scholar] [CrossRef]
- Hove, M.; Van Pouckea, C.; Njumbe-EdiageaL, E.; Nyanga, L.K.; De Saegera, S. Review on the natural co-occurrence of AFB1 and FB1 in maize and the combined toxicity of AFB1 and FB1. Food Control 2016, 59, 675–682. [Google Scholar] [CrossRef]
- Voss, K.A.; Smith, G.W.; Haschek, W.M. Fumonisins: Toxicokinetics, mechanism of action and toxicity. Anim. Feed Sci. Technol. 2007, 137, 299–325. [Google Scholar] [CrossRef]
- Abdallah, M.F.; Girgin, G.; Baydar, T. Occurrence, prevention and limitation of mycotoxins in feeds. Anim. Nutr. Feed Technol. 2015, 15, 471–490. [Google Scholar] [CrossRef]
- Liu, C.; Xu, W.; Liu, F.; Jiang, S. Fumonisins production by Fusarium proliferatum strains isolated from asparagus crown. Mycopathologia 2007, 164, 127–134. [Google Scholar] [CrossRef]
- Summerell, B.A.; Laurence, M.H.; Liew, E.C.Y.; Leslie, J.F. Biogeography and phylogeography of Fusarium: A review. Fungal Divers. 2010, 44, 3–13. [Google Scholar] [CrossRef]
- Li, J.; Jiang, G.; Yang, B.; Dong, X.; Feng, L.; Lin, S.; Chen, F.; Ashraf, M.; Jiang, Y. A luminescent bacterium assay of fusaric acid produced by Fusarium proliferatum from banana. Anal. Bioanal. Chem. 2012, 402, 1347–1354. [Google Scholar] [CrossRef]
- Arias, M.M.D.; Munkvold, G.P.; Ellis, M.L.; Leandro, L.F.S. Distribution and frequency of Fusarium species associated with soybean roots in Iowa. Plant Dis. 2013, 97, 1557–1562. [Google Scholar] [CrossRef] [PubMed]
- Chang, K.F.; Hwang, S.F.; Conner, R.L.; Ahmed, H.U.; Zhou, Q.; Turnbull, G.D.; Strelkov, S.E.; McLaren, D.L.; Gossen, B.D. First report of Fusarium proliferatum causing root rot in soybean (Glycine max L.) in Canada. Crop. Prot. 2015, 67, 52–58. [Google Scholar] [CrossRef]
- Busman, M.; Desjardins, A.E.; Proctor, R.H. Analysis of fumonisin contamination and the presence of Fusarium in wheat with kernel black point disease in the United States. Food Addit. Contam. 2012, 29, 1092–1100. [Google Scholar] [CrossRef] [PubMed]
- Fadl-Allah, E.; Stack, M.; Goth, R.; Bean, G. Production of fumonisins B1, B2 and B3 by Fusarium proliferatum isolated from rye grains. Mycotoxins Res. 1997, 13, 43–48. [Google Scholar] [CrossRef] [PubMed]
- Logrieco, A.; Moretti, A.; Castella, G.; Kostecki, M.; Golinski, P.; Ritieni, A.; Chelkowski, J. Beauvericin production by Fusarium species. Appl. Environ. Microbiol. 1998, 64, 3084–3088. [Google Scholar] [CrossRef]
- Han, Z.; Tangni, E.K.; Huybrechts, B.; Munaut, F.; Scauflaire, J.; Wu, A.; Callebaut, A. Screening survey of co-production of fusaric acid, fusarin C, and fumonisins B1, B2 and B3 by Fusarium strains grown in maize grains. Mycotoxin Res. 2014, 30, 231–240. [Google Scholar] [CrossRef]
- Kohut, G.; Olah, B.; Adam, A.L.; Garcia-Martinez, J.; Hornok, L. Adenylyl cyclase regulates heavy metal sensitivity, bikaverin production and plant tissue colonization in Fusarium proliferatum. J. Basic Microbiol. 2010, 50, 59–71. [Google Scholar] [CrossRef]
- Proctor, R.H.; Desjardins, A.E.; Mccormick, S.P.; Planttner, R.D. Genetic analysis of the role of trichothecene and fumonisin mycotoxins in the virulence of Fusarium. Eur. J. Plant Pathol. 2002, 108, 691–698. [Google Scholar] [CrossRef]
- Stepien, L.; Koczyk, G.; Waskiewicz, A. FUM cluster divergence in fumonisins-producing Fusarium species. Fungal Biol. 2011, 115, 112–123. [Google Scholar] [CrossRef]
- Rosler, S.M.; Sieber, C.M.; Humpf, H.U.; Tudzynski, B. Interplay between pathway-specific and global regulation of the fumonisin gene cluster in the rice pathogen Fusarium fujikuroi. Appl. Microbiol. Biotechnol. 2016, 100, 5869–5882. [Google Scholar] [CrossRef]
- Flaherty, J.E.; Woloshuk, C.P. Regulation of fumonisin biosynthesis in Fusarium verticillioides by a zinc binuclear cluster-type gene, ZFR1. Appl. Environ. Microbiol. 2004, 70, 2653–2659. [Google Scholar] [CrossRef]
- Bluhm, B.H.; Kim, H.; Butchko, R.A.E.; Woloshuk, C.P. Involvement of ZFR1 of Fusarium verticillioides in kernel colonization and the regulation of FST1, a putative sugar transporter gene required for fumonisin biosynthesis on maize kernels. Mol. Plant Pathol. 2008, 9, 203–211. [Google Scholar] [CrossRef]
- Sagaram, U.S.; Kolomiets, M.; Shim, W.B. Regulation of fumonisin biosynthesis in Fusarium verticillioides-maize system. Plant Pathol. J. 2006, 22, 203–210. [Google Scholar] [CrossRef]
- Li, T.; Gong, L.; Jiang, G.; Wang, Y.; Gupta, V.K.; Qu, H.; Duan, X.; Wang, J.; Jiang, Y. Carbon Sources Influence Fumonisin Production in Fusarium proliferatum. Proteomics 2017, 17, 33–37. [Google Scholar] [CrossRef]
- Stępien, L.; Waskiewicz, A.; Wilman, K. Host extract modulates metabolism and fumonisin biosynthesis by the plant-pathogenic fungus Fusarium proliferatum. Int. J. Food Microbiol. 2015, 193, 74–81. [Google Scholar] [CrossRef]
- Miyara, I.; Shafran, H.; Davidzon, M.; Sherman, A.; Prusky, D. pH regulation of ammonia secretion by Colletotrichum gloeosporioides and its effect on appressorium formation and pathogenicity. Mol. Plant-Microbe Interact. 2010, 23, 304–316. [Google Scholar] [CrossRef] [PubMed]
- Bi, F.; Barad, S.; Ment, D.; Luria, N.; Casado, V.; Galam, N.; Dubay, A. Carbon regulation of environmental pH by secreted small molecule effectors modulates pathogenicity in fungi. Mol. Plant Pathol. 2016, 17, 1178–1195. [Google Scholar] [CrossRef]
- Barad, S.; Horowitz, S.B.; Kobiler, I.; Sherman, A.; Prusky, D. Accumulation of the mycotoxin patulin in the presence of gluconic acid contributes to pathogenicity of penicillium expansum. Mol. Plant-Microbe Interact. 2014, 27, 66–77. [Google Scholar] [CrossRef]
- Prusky, D.; Bi, F.; Moral, J.; Barad, S. How does host carbon concentration modulate the lifestyle of postharvest pathogens during colonization? Front. Plant Sci. 2016, 7, 1306. [Google Scholar] [CrossRef]
- Cruz, A.; Marin, P.; Magan, N.; Gonzalez, M.T. Combined effects of benomyl and environmental factors on growth and expression of the fumonisin biosynthetic genes FUM1 and FUM19 by Fusarium verticillioides. Int. J. Food Microbiol. 2014, 191, 17–23. [Google Scholar] [CrossRef] [PubMed]
- Melcion, D.; Cahagnier, B.; Bakan, B.; Richard, D. Influence of temperature on fumonisin B1 production on maize grain by Fusarium proliferatum. Sci. Aliment. 1998, 18, 301–311. [Google Scholar]
- Kawakami, A.; Nakajima, T.; Hirayae, K. Effects of carbon sources and amines on induction of trichothecene production by Fusarium asiaticum in liquid culture. FEMS Microbiol. Lett. 2014, 352, 204–212. [Google Scholar] [CrossRef] [PubMed]
- Kohut, G.; Adam, A.L.; Fazekas, B.; Hornok, L. N-starvation stress induced FUM gene expression and fumonisin production is mediated via the HOG-type MAPK pathway in Fusarium proliferatum. Int. J. Food Microbiol. 2009, 130, 65–69. [Google Scholar] [CrossRef]
- Prusky, D.; Wilson, R. Does increased nutritional carbon availability in fruit and foliar hosts contribute to modulation of pathogen colonization? Postharvest Biol. Technol. 2018, 145, 27–32. [Google Scholar] [CrossRef]
- Prusky, D. Pathogen quiescence in postharvest diseases. Annu. Rev. Phytopathol. 1996, 34, 413–434. [Google Scholar] [CrossRef] [PubMed]
- Li, T.; Gong, L.; Wang, Y.; Chen, F.; Gupta, V.K.; Jian, Q.; Duan, X.; Jiang, Y. Proteomics analysis of Fusarium proliferatum under various initial pH during fumonisin production. J. Proteom. 2017, 164, 59–72. [Google Scholar] [CrossRef] [PubMed]
- Zong, Y.; Li, B.; Tian, S. Effects of carbon, nitrogen and ambient pH on patulin production and related gene expression in Penicillium expansum. Int. J. Food Microbiol. 2015, 206, 102–108. [Google Scholar] [CrossRef]
- Fanelli, F.; Schmidt, M.; Haidukowski, M.; Geisen, R.; Logrieco, A.; Mule, G. Influence of light on growth, fumonisin biosynthesis and FUM1 gene expression by Fusarium proliferatum. Int. J. Food Microbiol. 2012, 153, 148–153. [Google Scholar] [CrossRef]
- Rocha, L.O.; Reis, G.M.; Fontes, L.C.; Piacentini, K.C. Association between FUM expression and fumonisin contamination in maize from silking to harvest. Crop Prot. 2017, 94, 77–82. [Google Scholar] [CrossRef]
- Alexander, N.J.; Proctor, R.H.; McCormick, S.P. Genes, gene clusters, and biosynthesis of trichothecenes and fumonisins in Fusarium. Toxin Rev. 2009, 28, 198–215. [Google Scholar] [CrossRef]
- Proctor, R.H.; Brown, D.W.; Plattner, R.D.; Desjardins, A.E. Co-expression of 15 contiguous genes delineates a fumonisin biosynthetic gene cluster in Gibberella moniliformis. Fungal Genet. Biol. 2003, 38, 237–249. [Google Scholar] [CrossRef]
- Stepien, L. The use of Fusarium secondary metabolite biosynthetic genes in chemotypic and phylogenetic studies. Crit. Rev. Microbiol. 2014, 40, 176–185. [Google Scholar] [CrossRef]
- Visentin, I.; Montis, V.; Doll, K.; Alabouvette, C.; Tamietti, G.; Karlovsky, P.; Cardinale, F. Transcription of genes in the biosynthetic pathway for Fumonisin mycotoxins is epigenetically and differentially regulated in the fungal maize pathogen Fusarium verticillioides. Eukaryot. Cell 2012, 11, 252–259. [Google Scholar] [CrossRef]
- Jayashree, T.; Subramanyam, C. Oxidative stress as a prerequisite for aflatoxin production by Aspergillus parasiticus. Free Radic. Biol. Med. 2000, 29, 981–985. [Google Scholar] [CrossRef]
- Li, T.; Jian, Q.; Chen, F.; Wang, Y.; Gong, L.; Duan, X.; Yang, B.; Jiang, Y. Influence of butylated hydroxyanisole on the growth, hyphal morphology, and the biosynthesis of fumonisins in Fusarium proliferatum. Front. Microbiol. 2016, 7, 1038. [Google Scholar] [CrossRef]
- John, A.; Yang, J.; Liu, J.; Jiang, Y.; Yang, B. The structure changes of water-soluble polysaccharides in papaya during ripening. Int. J. Biol. Macromol. 2018, 115, 152–156. [Google Scholar] [CrossRef]
- Zhang, Z.; Wang, X.; Han, Z.; Zhao, M.; Yin, L. Purification, antioxidant and moisture-preserving activities of polysaccharides from papaya. Carbohydr. Polym. 2012, 87, 2332–2337. [Google Scholar] [CrossRef]
- Jian, Q.; Gong, L.; Li, T.; Wang, Y. Rapid Assessment of the toxicity of fungal compounds using luminescent Vibrio qinghaiensis sp. Q67. Toxins 2017, 9, 335. [Google Scholar] [CrossRef]
- Li, T.; Jiang, G.; Qu, H.; Wang, Y. Comparative transcriptome analysis of Penicillium citrinum cultured with different carbon sources identifies genes involved in citrinin biosynthesis. Toxins 2017, 9, 69. [Google Scholar] [CrossRef]

| Gene | Description | Sequence of Primer (5’ to 3’) |
|---|---|---|
| FUM1 | Polyketide synthase | For: ACTTTGCCATTTCCAACCGTAT |
| Rev: GGGAGTTTTTCCATCCGAATTT | ||
| FUM6 | Cytochrome P450 Monooxygenase | For: CGCTGGTACAGAAACGACGGCTAC |
| Rev: TCGCGTAGGCACGCACTGAGATA | ||
| FUM8 | Aminotransferase | For: ATTCCATGAGGAGGCAATGCAG |
| Rev: GGTGCTATTCCTTCGAGGTCAC | ||
| FUM9 | Dioxygenase | For: GAGCGTGGATGCTTGGCTGTTACT |
| Rev: GGACTGGGAGCTTCTTTGCGGTATC | ||
| FUM15 | Cytochrome P450 monooxygenase | For: CCATTCCACTCACGATGCGAGAAGC |
| Rev: GCCAGGATTATTCTAGTGCCAGCAGGTA | ||
| FUM18 | Longevity assurance factor | For: TGGTAGATGATGTGAGGAGCGACGA |
| Rev: TCAAGTAGCCGTTGCCGTCATTCC | ||
| FUM19 | ABC transporter | For: GGCTATGGATTCGGACGCTCTCAG |
| Rev: ACCGTGCTGTGCTTGACCTAACATC | ||
| FUM related TF | Transcription factor | For: GCGGTGGAGGTGTCGGATTGAGTAA |
| Rev: TGTCGGTGGAGGTAATGTAGTGGCTATTC | ||
| ZFR1 | ZFR1 regulator of fumonisin biosynthesis | For: GCTCGTCTTCTCCTACATCGGCATCA |
| Rev: CGGAATATGTGCGTTGTCAACAAGGTAGT | ||
| FUM related Zn(II)2Cys6 | Fumonisin biosynthetic Related Zn(II)2Cys6 protein | For: CAACTGCCAATAGCGAGGATGTGATGTC |
| Rev: GACCTTCTCAACAATCCCGATTCCATTAC | ||
| Histone H3 | Histone H3 | For: ACTAAGCAGACCGCCCGCAGG |
| Rev: GCGGGCGAGCTGGATGTCCTT |
© 2019 by the authors. Licensee MDPI, Basel, Switzerland. This article is an open access article distributed under the terms and conditions of the Creative Commons Attribution (CC BY) license (http://creativecommons.org/licenses/by/4.0/).
Share and Cite
Wu, Y.; Li, T.; Gong, L.; Wang, Y.; Jiang, Y. Effects of Different Carbon Sources on Fumonisin Production and FUM Gene Expression by Fusarium proliferatum. Toxins 2019, 11, 289. https://doi.org/10.3390/toxins11050289
Wu Y, Li T, Gong L, Wang Y, Jiang Y. Effects of Different Carbon Sources on Fumonisin Production and FUM Gene Expression by Fusarium proliferatum. Toxins. 2019; 11(5):289. https://doi.org/10.3390/toxins11050289
Chicago/Turabian StyleWu, Yu, Taotao Li, Liang Gong, Yong Wang, and Yueming Jiang. 2019. "Effects of Different Carbon Sources on Fumonisin Production and FUM Gene Expression by Fusarium proliferatum" Toxins 11, no. 5: 289. https://doi.org/10.3390/toxins11050289
APA StyleWu, Y., Li, T., Gong, L., Wang, Y., & Jiang, Y. (2019). Effects of Different Carbon Sources on Fumonisin Production and FUM Gene Expression by Fusarium proliferatum. Toxins, 11(5), 289. https://doi.org/10.3390/toxins11050289

